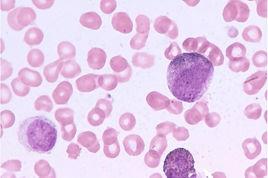
慢淋 慢淋

診斷
(一)病史及症狀⑴ 病史提問:起病緩慢,病人多無明顯症狀,問診應注意是否有低熱、盜汗,易感染表現。⑵ 臨床症狀:乏力、消瘦、納差、盜汗、體力減退、發熱,偶有皮膚瘙癢。
(二)體檢發現:全身淋巴結腫大,質中等硬、可移動,晚期相互粘連融合;肝脾輕度腫大,晚期脾臟明顯腫大。骨痛不明顯。晚期皮膚可見出血點。
(三)輔助檢查1. 血象:正細胞正色素貧血。白細胞計數>10×109/L,分類:淋巴細胞>50%,絕對值>5.0×109/L;以成熟淋巴細胞為主,可見幼稚淋巴細胞及異型淋巴細胞。血小板正常或減少。2. 骨髓象:增生活躍至極度活躍,以成熟淋巴細胞增生明顯,占40%以上,原、幼稚淋巴細胞10%。紅系、粒系相對減少,巨核細胞正常或減少。3. 血免疫球蛋白減少;或為單株免疫球蛋白增高,多為IgM型。κ輕鏈或λ輕鏈檢測陽性。
(四)CLL臨床分期及鑑別診斷1.分期:Ⅰ期:淋巴細胞增多,可伴有淋巴結腫大。Ⅱ期:Ⅰ期+肝大或脾大。Ⅲ期:Ⅰ期或Ⅱ期+貧血(血紅蛋白100g/L)或/和血小板減少(100×109/L)。2. 鑑別診斷應與結核性淋巴結炎、淋巴瘤、傳染性單核細胞增多症、毛細胞白血病、幼淋巴細胞白血病等鑑別。
白細胞計數>10×109/L,9應該是上標
治療
臨床分期 慢淋分期的目的是為了指導臨床治療和估計預後。目前通用的國際臨床分期標準如下:
A期
血液中淋巴細胞≥15×10 9/L,骨髓中淋巴細胞≥40%。無貧血或血小板減少。淋巴結腫大小於3個區域(頸、腋下、腹腔的淋巴結不論一側或兩側,肝、脾各為一個區域)。
B期
血液和骨髓同上。淋巴結腫大累及3個或更多區域。
C期
血液和骨髓中淋巴細胞同上,但有貧血(血紅蛋白,男性<110g/L,女性<100g/L)或血小板減少(<100×109/L)。淋巴結累及範圍不計。
治療 A期病人不需要治療,但應定期觀察病情是否有進展。B期和C期病人均需治療。
1.化學治療:CLB(苯丁酸氮芥)套用最廣,用法為①0.1~0.2mg/kg.d,口服,連用6~12天,2周后減至2~4mg/d,長期維持。②間歇療法,0.2mg/kg.d,口服,連用10~14天,休息2周重複給藥。亦可用聯合化療,用CLB十PDN(潑尼松),CLB0.1~0.2mg/kg.d與PDN10~20mg/d,連用4天,每3周一次。亦可用M12方案,即BCUN(卡氮芥)0.5~1mg/kg,靜注,第1天;CTX(環磷醯胺)10mg/kg靜注,第2天;L~PAM(苯丙氨酸氮芥)0.25mg/kg.d,口服,第1~14天;VCR(長春新鹼)0.03mg/kg靜注,第21天;PDN1mg/kg.d,口服,第l~14天。停藥4周后可重複。晚期病例用VCR+CTX+CLB+PDN聯合治療,病人經化療後大多能達到症狀減輕,淋巴結和脾臟縮小,白細胞計數下降。但即使白細胞計數正常,血液和骨髓中淋巴細胞百分數仍增高,血清球蛋白減少,淋巴結和脾輕度腫大常持續存在。停藥後數周內即復發的病人需連續不斷地治療。
2.放射治療:主要用於淺表或深部淋巴結腫大或脾大經上述化療而療效不顯著。如有壓迫或阻塞症狀,亦需採用局部放射治療,效果較好。用60Co作全身照射也能使部分病人緩解,不過現在臨床上很少套用。
慢性淋巴細胞白血病患者有明顯淋巴結腫大(包括縱橫或巨脾者)可考慮採用局部照射,以緩解壓迫症狀。Sparr 等套用胸線照射22例,完全緩解11例,部分緩解7例。HEILMANN套用體外血細胞照射治療12例,發現B淋巴細胞數明顯降低,而T淋巴細胞無改變,但需要特殊設備。放射性32P僅對化療無效者考慮採用,劑量應小於其他類型白血病,每次1-2豪居里,每周1-2次。
3.其他治療:如並發自身免疫性貧血或血小板減少,應採用糖皮質激素治療,療效尚佳。或經脾區放療無效時可考慮脾切除術,術後淋巴細胞變化不大,但血紅蛋白和血小板計數常能上升。如有反覆感染或嚴重感染,可套用抗生素。低丙種球蛋白血症者可定期給予丙種球蛋白。另外,中成藥六神丸也有一定療效。再有,F1udarabin是一種新的臨床試用的製劑,對其他製劑耐藥物病例可試用本品。
症狀體徵
症狀和體徵往往較血象發生明顯改變晚些出現。慢淋是一種中年以上人的疾病,約90%的患者年齡超過50歲,平均年齡為65歲。許多病人是偶然發現淋巴細胞增多。最早出現的症狀常常是乏力、疲倦、體力活動時氣促。淺表淋巴結特別是頸部淋巴結腫大,常首先引起病人的注意,晚期成串成堆,直徑可達2~3cm,無壓痛、質硬、可移動。腸系膜或腹膜後淋巴結可引起腹部或泌尿系統症狀。脾輕至中度腫大,肝亦可腫大,但不如慢粒顯著。稍晚出現食慾減退、消瘦、低熱、盜汗、貧血等症狀。約10%或以上病人可發生自體免疫性溶血性貧血,此時貧血常較嚴重,並可出現黃疸。晚期可有皮膚紫癜和出血傾向,易感染,尤其是呼吸道感染。這與正常免疫球蛋白的產生減少有關,可能成為死亡的直接原因。另外胃腸道、骨骼系統可出現不同程度的損害。有些病人有皮膚瘙癢。偶見白血病性皮膚浸潤,表現為紫紅色或棕紅色結節或皮膚增厚。全身皮膚對以發紅、扁桃體、唾液腺或淚腺也可腫大。
輔助檢查
血象中白細胞增多是本病的特點,最突出的發現是小淋巴細胞增多,白細胞計數大多在15~50×109/L,少數可超過100×109 /L。早期、小淋巴細胞占白細胞的65%~75%,晚期90%~98%,其形態與正常的小淋巴細胞難以區別。中性粒細胞和其他正常白細胞均顯著減少。早期,貧血可不存在,以後逐漸加重,晚期貧血可以很嚴重,網織紅細胞增高,血清膽紅素增加。晚期血小板計數常減低。骨髓象:早期白血病細胞僅在少數骨髓腔內出現,因此,早期骨髓象可無明顯改變;晚期正常的骨髓細胞幾乎全部被成熟的小淋巴細胞所代替,原始淋巴細胞和幼稚淋巴細胞僅占5%~10%。另外,50%的病例有丙種球蛋白減少;10%~20%的病人有自身抗體;30%患者有高尿酸血症。
預後
病程長短很不一致,從3~5年至10餘年不等,平均約5~20年(從診斷成立時算起)。其主要死亡原因為骨髓功能衰竭引起的嚴重貧血、出血或感染,以肺部感染最為多見。